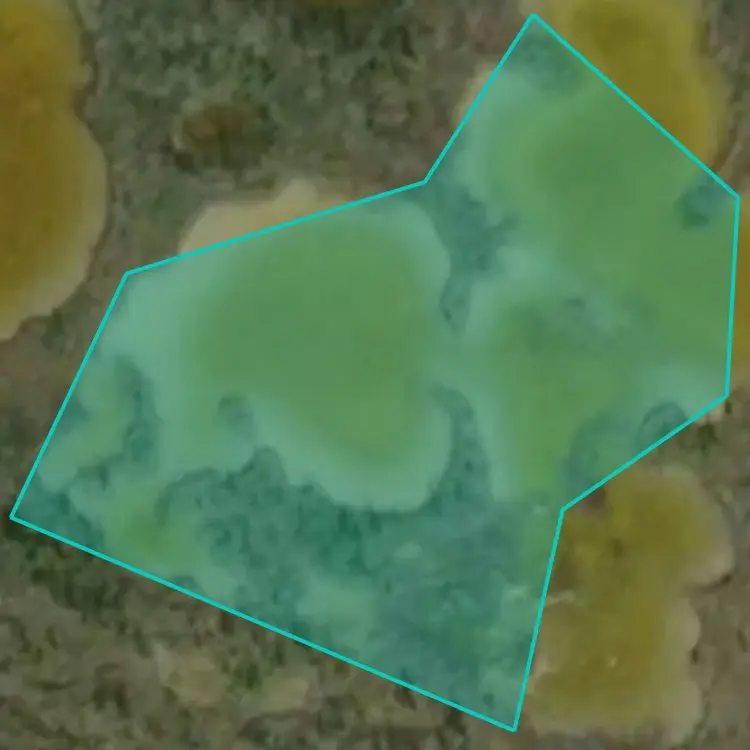

Popular Fishing Spots Near Swampy Lakes

Swampy Lakes
0.1 mi away • Fort Smith, Northwest Territories

Swampy Lakes
0.1 mi away • Fort Smith, Northwest Territories

Swampy Lakes
0.1 mi away • Fort Smith, Northwest Territories

Swampy Lakes
0.2 mi away • Fort Smith, Northwest Territories

Swampy Lakes
0.1 mi away • Fort Smith, Northwest Territories

Swampy Lakes
0.3 mi away • Fort Smith, Northwest Territories

Swampy Lakes
0.2 mi away • Fort Smith, Northwest Territories

Swampy Lakes
0.3 mi away • Fort Smith, Northwest Territories